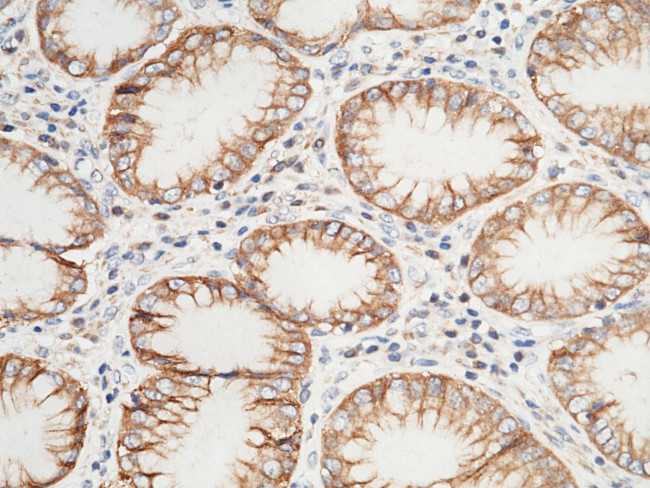
VSIG2 Antibody in Immunohistochemistry (Paraffin) (IHC (P))

Search
Invitrogen
VSIG2 Polyclonal Antibody
{{$productOrderCtrl.translations['antibody.pdp.commerceCard.promotion.promotions']}}
{{$productOrderCtrl.translations['antibody.pdp.commerceCard.promotion.viewpromo']}}
{{$productOrderCtrl.translations['antibody.pdp.commerceCard.promotion.promocode']}}: {{promo.promoCode}} {{promo.promoTitle}} {{promo.promoDescription}}. {{$productOrderCtrl.translations['antibody.pdp.commerceCard.promotion.learnmore']}}
产品信息
PA5-81116
宿主/亚型
分类
类型
抗原
偶联物
形式
浓度
保存条件
运输条件
RRID
产品详细信息
This product is preservative free. It is recommended to add sodium azide to avoid contamination (final concentration 0.05%-0.1%).
This antibody has specificity for Human VSIG2/CTXL.
靶标信息
CTXL, a cortical thymocyte marker, is a member of the immunoglobulin (Ig) superfamily and has features of both antigen specific receptors and adhesion molecules. This single pass, type I protein contains a signal peptide, an extracellular V type Ig like domain followed by a C2 type Ig like domain and a cytoplasmic tail. Expression levels of CTXL are high in the stomach, colon, prostate, trachea, and thyroid gland, with lower levels observed in bladder and lung tissues. CTXL is not expressed in the thymus. CTXL is developmentally regulated and may be involved in thymocyte selection. It localizes to junctional complexes between endothelial and epithelial cells and may play a role in cell-cell adhesion and transmigration of leukocytes.
仅用于科研。不用于诊断过程。未经明确授权不得转售。